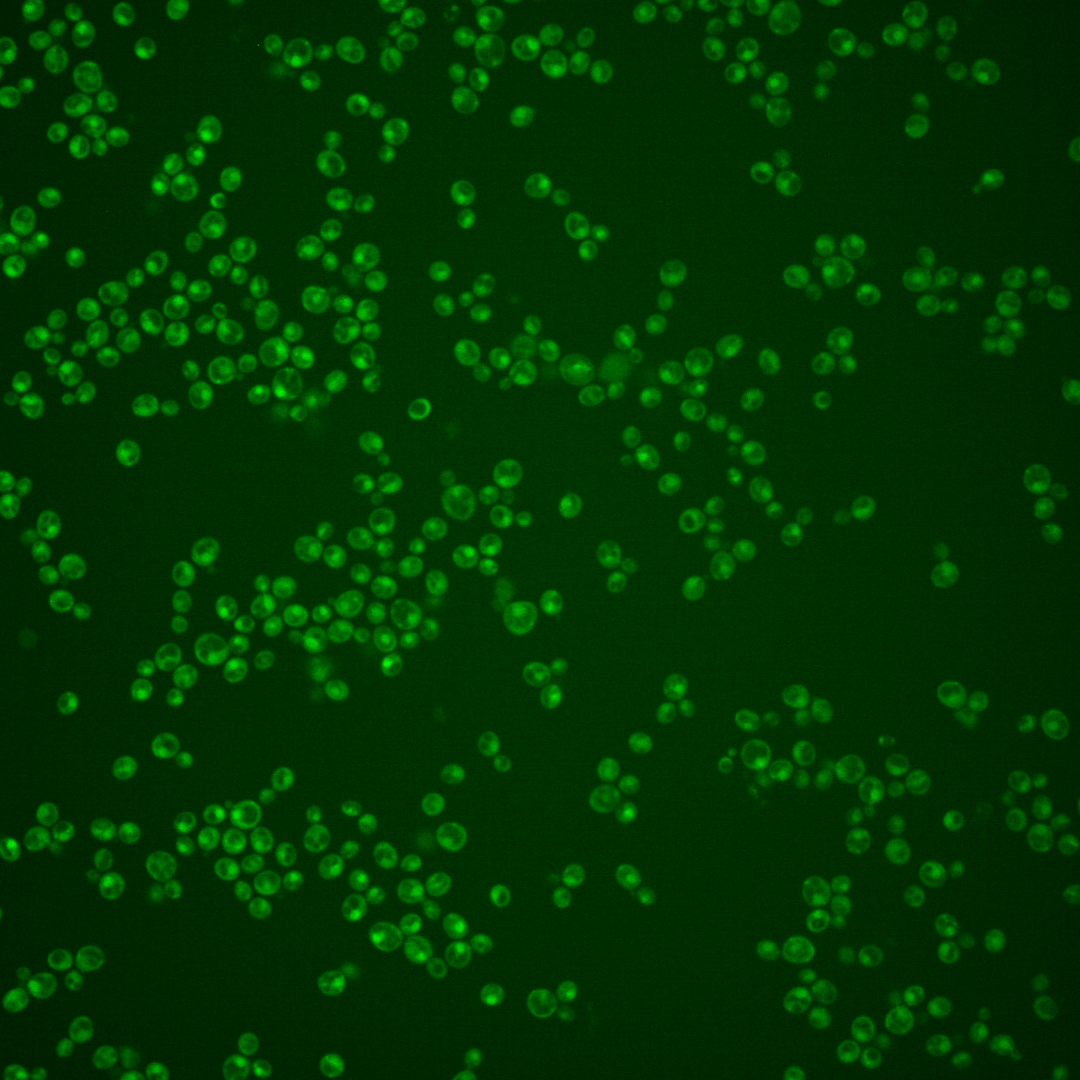
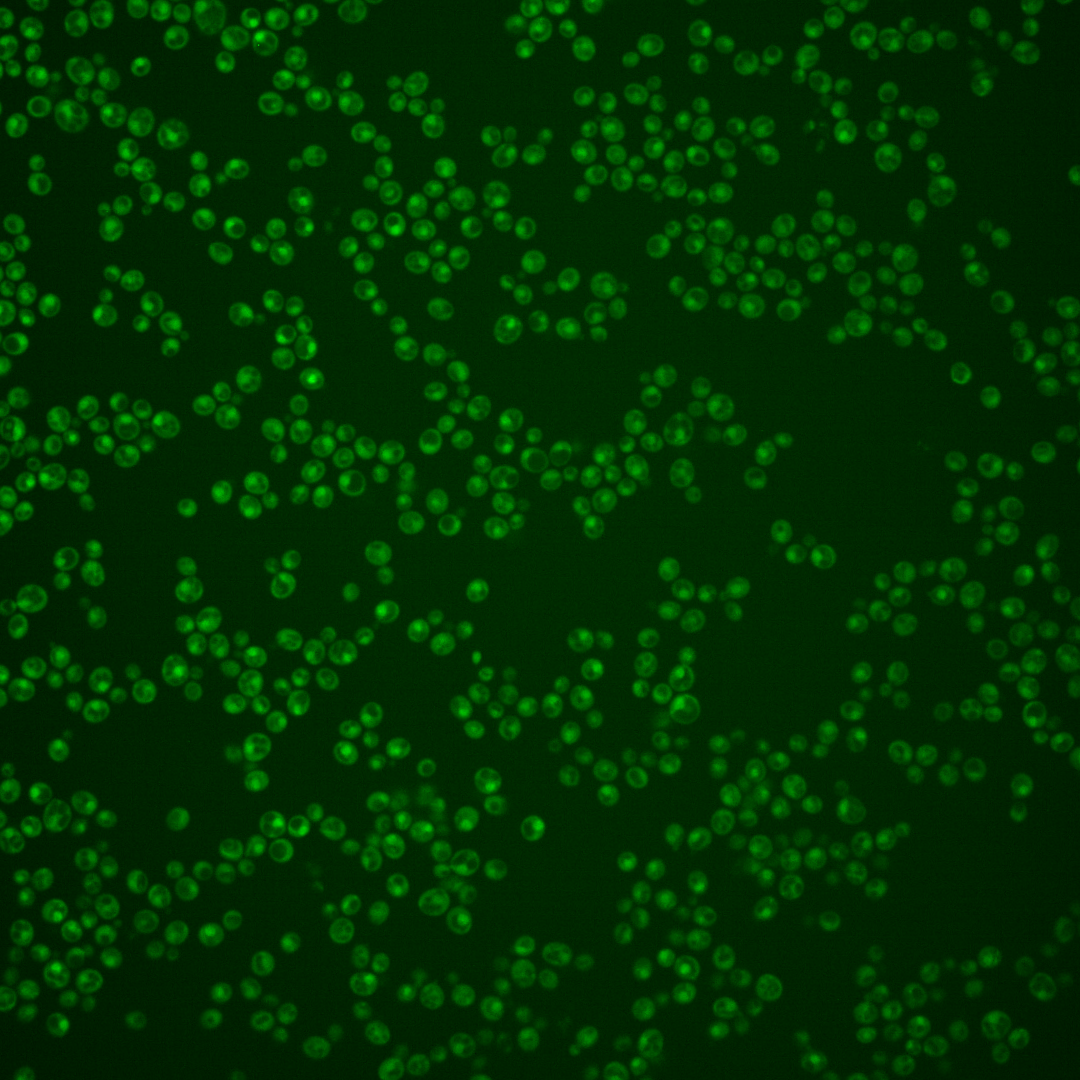
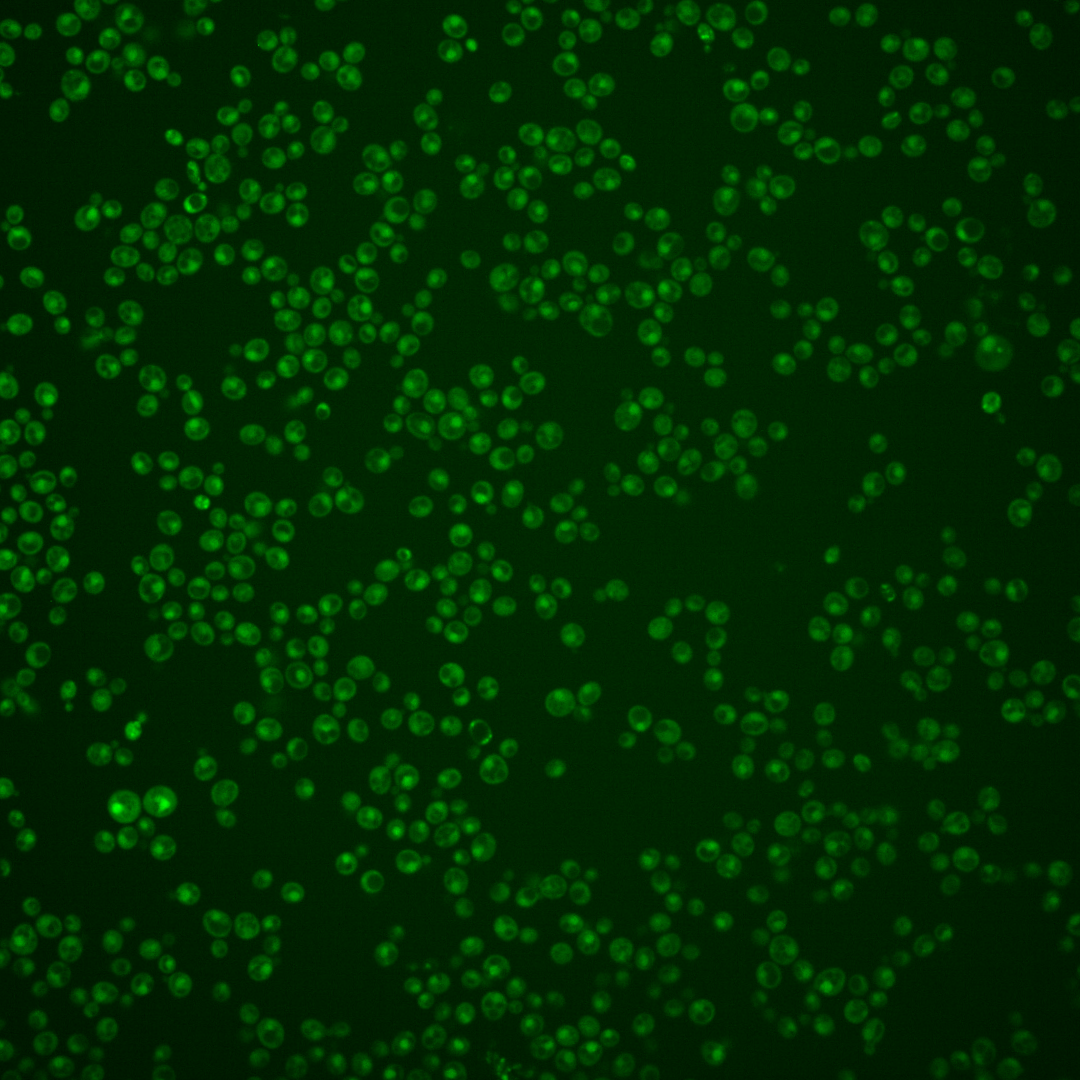
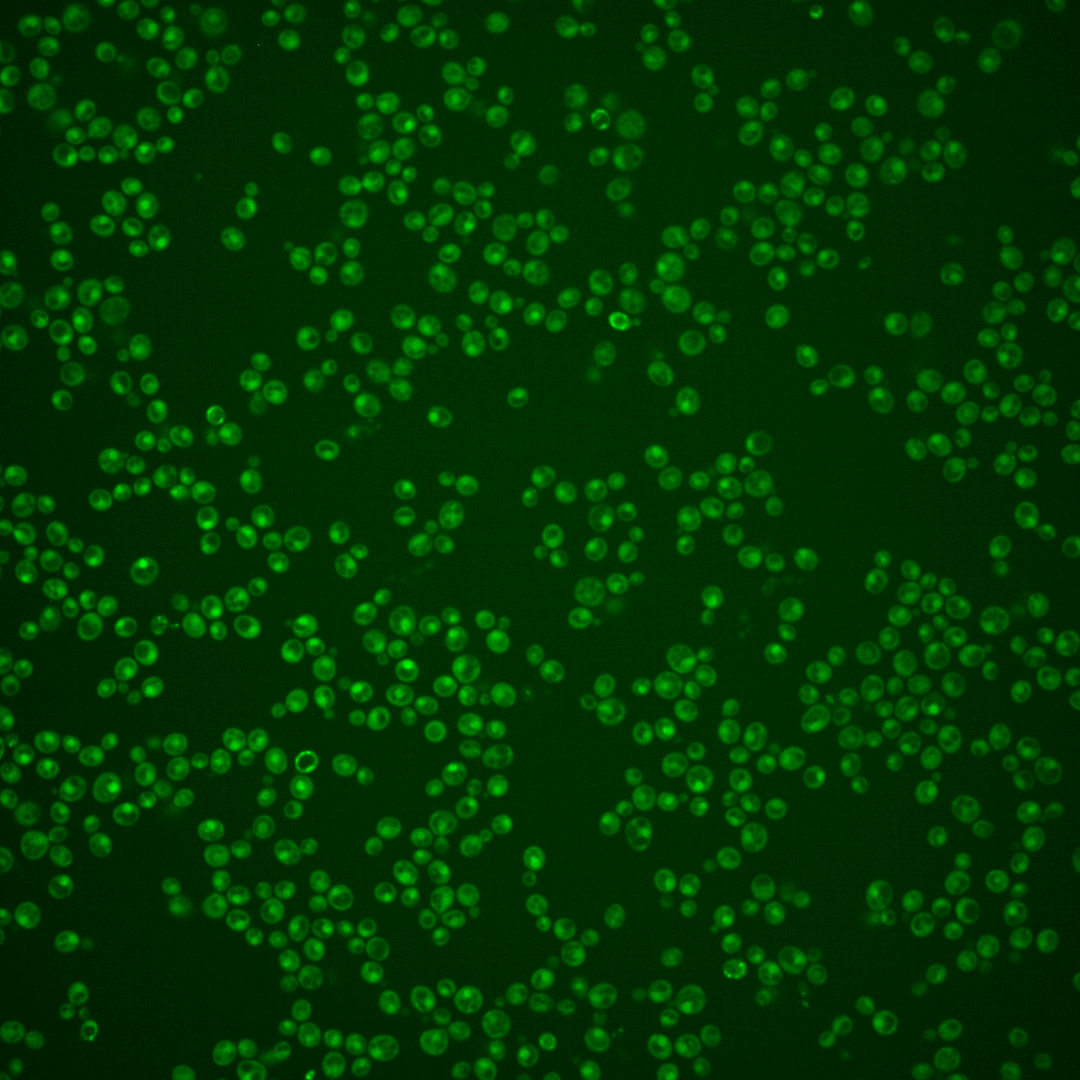

| Standard name | |
|---|---|
| Human Ortholog | |
| Description | Zinc-finger DNA-binding transcription factor; targets strong transcriptional activator Met4p to promoters of sulfur metabolic genes; involved in transcriptional regulation of the methionine biosynthetic genes; feedforward loop controlling expression of MET32 and the lack of such a loop for MET31 may account for the differential actions of Met31p and Met32p; MET31 has a paralog, MET32, that arose from the whole genome duplication |
Micrographs




















































































Sub-cellular Localization
Yeast GFP Assignment
Protein Abundance
Localization Change
External localization resources
| ensLOC | DeepLoc | |||||||||||||||||||||||
|---|---|---|---|---|---|---|---|---|---|---|---|---|---|---|---|---|---|---|---|---|---|---|---|---|
| Localization | WT1 | WT2 | WT3 | RAP60 | RAP140 | RAP220 | RAP300 | RAP380 | RAP460 | RAP540 | RAP620 | RAP700 | HU80 | HU120 | HU160 | rpd3Δ_1 | rpd3Δ_2 | rpd3Δ_3 | WT1 | WT2 | WT3 | AF100 | AF140 | AF180 |
| Cortical Patches | 0 | 0 | 0 | 0 | 0 | 0 | 0 | 0 | 0 | 0 | 0 | 0 | 0 | 0 | 0 | 0 | 0 | 0 | 0 | 0 | 0 | 1 | 1 | 0 |
| Bud | 0 | 0 | 0 | 1 | 0 | 2 | 2 | 3 | 1 | 2 | 2 | 1 | 0 | 0 | 0 | 1 | 0 | 0 | 0 | 3 | 2 | 8 | 12 | 18 |
| Bud Neck | 0 | 0 | 2 | 0 | 2 | 2 | 2 | 9 | 1 | 3 | 0 | 0 | 0 | 0 | 1 | 0 | 0 | 0 | 1 | 0 | 0 | 1 | 3 | 7 |
| Bud Site | 0 | 0 | 0 | 0 | 0 | 5 | 0 | 3 | 0 | 0 | 0 | 4 | 0 | 0 | 0 | 0 | 0 | 0 | – | – | – | – | – | – |
| Cell Periphery | 0 | 0 | 0 | 0 | 0 | 0 | 0 | 1 | 0 | 0 | 0 | 0 | 0 | 0 | 0 | 1 | 0 | 0 | 0 | 0 | 0 | 0 | 0 | 0 |
| Cytoplasm | 14 | 48 | 28 | 89 | 132 | 117 | 229 | 353 | 91 | 141 | 79 | 98 | 151 | 194 | 314 | 54 | 35 | 42 | 28 | 45 | 17 | 92 | 150 | 130 |
| Endoplasmic Reticulum | 3 | 0 | 1 | 0 | 0 | 0 | 0 | 0 | 0 | 0 | 0 | 0 | 2 | 0 | 1 | 21 | 12 | 11 | 0 | 0 | 1 | 1 | 3 | 2 |
| Endosome | 0 | 0 | 1 | 16 | 11 | 2 | 7 | 10 | 2 | 1 | 1 | 2 | 9 | 24 | 30 | 8 | 10 | 6 | 2 | 3 | 2 | 5 | 10 | 14 |
| Golgi | 0 | 0 | 0 | 0 | 0 | 0 | 0 | 0 | 0 | 0 | 0 | 1 | 1 | 0 | 0 | 0 | 3 | 0 | 1 | 1 | 1 | 0 | 0 | 1 |
| Mitochondria | 15 | 20 | 0 | 17 | 9 | 79 | 54 | 128 | 46 | 63 | 91 | 68 | 23 | 13 | 18 | 19 | 21 | 16 | 10 | 8 | 13 | 22 | 32 | 35 |
| Nucleus | 7 | 78 | 18 | 46 | 32 | 18 | 25 | 25 | 6 | 5 | 8 | 12 | 195 | 273 | 293 | 254 | 169 | 187 | 23 | 82 | 27 | 146 | 213 | 220 |
| Nuclear Periphery | 0 | 0 | 0 | 0 | 0 | 0 | 0 | 0 | 0 | 0 | 0 | 0 | 0 | 0 | 0 | 1 | 0 | 0 | 0 | 0 | 0 | 1 | 1 | 1 |
| Nucleolus | 0 | 0 | 0 | 0 | 0 | 0 | 0 | 4 | 1 | 0 | 2 | 2 | 0 | 0 | 0 | 0 | 1 | 0 | 0 | 1 | 0 | 12 | 14 | 15 |
| Peroxisomes | 0 | 0 | 0 | 0 | 0 | 0 | 0 | 0 | 0 | 0 | 0 | 0 | 0 | 0 | 0 | 0 | 0 | 0 | 0 | 0 | 0 | 0 | 0 | 0 |
| SpindlePole | 0 | 0 | 2 | 4 | 5 | 1 | 11 | 8 | 1 | 8 | 5 | 4 | 4 | 2 | 2 | 1 | 2 | 1 | 3 | 9 | 5 | 27 | 42 | 49 |
| Vac/Vac Membrane | 7 | 33 | 14 | 22 | 30 | 2 | 34 | 22 | 6 | 6 | 10 | 6 | 36 | 61 | 102 | 40 | 33 | 26 | 24 | 52 | 17 | 76 | 125 | 142 |
| Unique Cell Count | 38 | 161 | 61 | 179 | 199 | 191 | 327 | 508 | 135 | 197 | 157 | 166 | 399 | 537 | 729 | 349 | 250 | 260 | 103 | 212 | 98 | 408 | 624 | 658 |
| Labelled Cell Count | 46 | 179 | 66 | 195 | 221 | 228 | 364 | 566 | 155 | 229 | 198 | 198 | 421 | 567 | 761 | 400 | 286 | 289 | 103 | 212 | 98 | 408 | 624 | 658 |
Yeast GFP Assignment
Protein Abundance
| Screen | WT1 | WT2 | WT3 | RAP60 | RAP140 | RAP220 | RAP300 | RAP380 | RAP460 | RAP540 | RAP620 | RAP700 | HU80 | HU120 | HU160 | rpd3Δ_1 | rpd3Δ_2 | rpd3Δ_3 | AF100 | AF140 | AF180 |
|---|---|---|---|---|---|---|---|---|---|---|---|---|---|---|---|---|---|---|---|---|---|
| Mean Cell GFP Intensity (1e-4) | 3.5 | 4.2 | 5.1 | 5.2 | 5.5 | 3.6 | 4.3 | 4.2 | 3.9 | 4.1 | 3.9 | 4.3 | 4.6 | 4.7 | 4.7 | 6.1 | 6.1 | 6.3 | 4.1 | 4.2 | 4.2 |
| Std Deviation (1e-4) | 0.5 | 0.6 | 0.9 | 1.7 | 1.9 | 1.4 | 1.2 | 1.4 | 1.5 | 1.7 | 1.6 | 2.2 | 1.0 | 1.1 | 0.9 | 1.4 | 1.5 | 1.4 | 0.8 | 1.1 | 1.1 |
| Intensity Change (Log2) | – | – | – | 0.03 | 0.12 | -0.48 | -0.23 | -0.27 | -0.37 | -0.3 | -0.36 | -0.24 | -0.12 | -0.1 | -0.09 | 0.28 | 0.27 | 0.31 | -0.31 | -0.27 | -0.25 |
Localization Change
| Localization | RAP60 | RAP140 | RAP220 | RAP300 | RAP380 | RAP460 | RAP540 | RAP620 | RAP700 | HU80 | HU120 | HU160 | rpd3Δ_1 | rpd3Δ_2 | rpd3Δ_3 |
|---|---|---|---|---|---|---|---|---|---|---|---|---|---|---|---|
| Actin | – | – | – | – | – | – | – | – | – | – | – | – | – | – | – |
| Bud | – | – | – | – | – | – | – | – | – | – | – | – | 0 | 0 | 0 |
| Bud Neck | – | – | – | – | – | – | – | – | – | – | – | – | 0 | 0 | 0 |
| Bud Site | – | – | – | – | – | – | – | – | – | – | – | – | 0 | 0 | 0 |
| Cell Periphery | – | – | – | – | – | – | – | – | – | – | – | – | 0 | 0 | 0 |
| Cyto | – | – | – | – | – | – | – | – | – | – | – | – | – | – | – |
| Endoplasmic Reticulum | – | – | – | – | – | – | – | – | – | – | – | – | 0 | 0 | 0 |
| Endosome | – | – | – | – | – | – | – | – | – | – | – | – | 0 | 0 | 0 |
| Golgi | – | – | – | – | – | – | – | – | – | – | – | – | 0 | 0 | 0 |
| Mitochondria | – | – | – | – | – | – | – | – | – | – | – | – | 0 | 0 | 0 |
| Nuclear Periphery | – | – | – | – | – | – | – | – | – | – | – | – | 0 | 0 | 0 |
| Nuc | – | – | – | – | – | – | – | – | – | – | – | – | – | – | – |
| Nucleolus | – | – | – | – | – | – | – | – | – | – | – | – | 0 | 0 | 0 |
| Peroxisomes | – | – | – | – | – | – | – | – | – | – | – | – | 0 | 0 | 0 |
| SpindlePole | – | – | – | – | – | – | – | – | – | – | – | – | 0 | 0 | 0 |
| Vac | – | – | – | – | – | – | – | – | – | – | – | – | – | – | – |
| Cortical Patches | – | – | – | – | – | – | – | – | – | – | – | – | 0 | 0 | 0 |
| Cytoplasm | – | – | – | – | – | – | – | – | – | – | – | – | 0 | 0 | 0 |
| Nucleus | – | – | – | – | – | – | – | – | – | – | – | – | 0 | 0 | 0 |
| Vacuole | – | – | – | – | – | – | – | – | – | – | – | – | -2.4 | -1.9 | -2.8 |
External localization resources
Images






























Protein Concentration and Protein Localization Data
| R1 | R2 | R3 | ||||||||||||||||
|---|---|---|---|---|---|---|---|---|---|---|---|---|---|---|---|---|---|---|
| G1 Pre-START | G1 Post-START | S/G2 | Metaphase | Anaphase | Telophase | G1 Pre-START | G1 Post-START | S/G2 | Metaphase | Anaphase | Telophase | G1 Pre-START | G1 Post-START | S/G2 | Metaphase | Anaphase | Telophase | |
| Concentration | -0.0405 | -0.1291 | -0.2738 | -0.619 | -0.7225 | -0.37 | 0.5473 | 0.7786 | 0.796 | 0.4467 | 0.6323 | 0.6827 | 3.1902 | 2.612 | 2.4744 | 2.4275 | 2.6875 | 2.7622 |
| Actin | 0.0112 | 0.0003 | 0.0002 | 0.0002 | 0.0001 | 0.0002 | 0.0002 | 0.0001 | 0.0001 | 0.0001 | 0.0001 | 0.0001 | 0.0381 | 0.0009 | 0.002 | 0.006 | 0.0044 | 0.0097 |
| Bud | 0.0003 | 0.0001 | 0 | 0 | 0 | 0 | 0 | 0 | 0 | 0 | 0 | 0 | 0.0004 | 0.0013 | 0.0002 | 0.0005 | 0.0001 | 0.0001 |
| Bud Neck | 0.0043 | 0.0007 | 0.0004 | 0.0004 | 0.0008 | 0.0017 | 0.0004 | 0.0003 | 0.0002 | 0.0005 | 0.0004 | 0.0013 | 0.0085 | 0.001 | 0.0012 | 0.0067 | 0.0072 | 0.0023 |
| Bud Periphery | 0.0007 | 0.0001 | 0 | 0 | 0 | 0 | 0.0001 | 0 | 0 | 0 | 0 | 0 | 0.0007 | 0.0006 | 0.0003 | 0.0019 | 0.0001 | 0.0001 |
| Bud Site | 0.001 | 0.0009 | 0.0001 | 0.0001 | 0.0001 | 0 | 0.0001 | 0.0004 | 0.0002 | 0 | 0.0001 | 0.0001 | 0.002 | 0.0034 | 0.0018 | 0.0039 | 0.0007 | 0.0002 |
| Cell Periphery | 0.0001 | 0 | 0 | 0 | 0 | 0 | 0 | 0 | 0 | 0 | 0 | 0 | 0.0002 | 0.0001 | 0.0001 | 0.0031 | 0 | 0 |
| Cytoplasm | 0.0257 | 0.0481 | 0.0229 | 0.0318 | 0.0252 | 0.0083 | 0.0175 | 0.03 | 0.0103 | 0.0249 | 0.0184 | 0.0115 | 0.0458 | 0.0676 | 0.0459 | 0.0565 | 0.0246 | 0.0253 |
| Cytoplasmic Foci | 0.0038 | 0.001 | 0.0006 | 0.0009 | 0.0009 | 0.0004 | 0.0006 | 0.0008 | 0.0002 | 0.0009 | 0.0003 | 0.0018 | 0.0064 | 0.0045 | 0.0063 | 0.0089 | 0.0161 | 0.0032 |
| Eisosomes | 0.0002 | 0.0001 | 0 | 0 | 0 | 0.0001 | 0 | 0 | 0 | 0 | 0 | 0 | 0.0003 | 0.0002 | 0.0002 | 0.0006 | 0.0001 | 0.0002 |
| Endoplasmic Reticulum | 0.0037 | 0.0022 | 0.0009 | 0.0008 | 0.0006 | 0.0003 | 0.0005 | 0.0008 | 0.0002 | 0.0004 | 0.0005 | 0.0002 | 0.0031 | 0.0028 | 0.0011 | 0.0013 | 0.001 | 0.0009 |
| Endosome | 0.0065 | 0.0021 | 0.001 | 0.0014 | 0.0012 | 0.0004 | 0.0013 | 0.0014 | 0.0003 | 0.0007 | 0.0006 | 0.0022 | 0.0106 | 0.0031 | 0.0055 | 0.005 | 0.0046 | 0.004 |
| Golgi | 0.0008 | 0.0001 | 0 | 0 | 0 | 0 | 0 | 0 | 0 | 0 | 0 | 0.0001 | 0.0053 | 0.0002 | 0.0019 | 0.0029 | 0.0023 | 0.0016 |
| Lipid Particles | 0.0035 | 0.0012 | 0.0002 | 0.0001 | 0.0001 | 0 | 0.0001 | 0.0002 | 0 | 0.0001 | 0.0001 | 0.0004 | 0.0038 | 0.0005 | 0.0043 | 0.0082 | 0.005 | 0.0022 |
| Mitochondria | 0.0031 | 0.0047 | 0.0003 | 0.0004 | 0.0004 | 0.0001 | 0.0005 | 0.0003 | 0.0002 | 0.0002 | 0.0004 | 0.0001 | 0.0017 | 0.0009 | 0.0015 | 0.0103 | 0.0005 | 0.0008 |
| None | 0.056 | 0.0922 | 0.0781 | 0.0332 | 0.101 | 0.0332 | 0.0597 | 0.0536 | 0.0244 | 0.033 | 0.0614 | 0.0185 | 0.0679 | 0.2175 | 0.1195 | 0.0753 | 0.2065 | 0.0495 |
| Nuclear Periphery | 0.0246 | 0.0288 | 0.0173 | 0.0102 | 0.0333 | 0.0059 | 0.0086 | 0.0126 | 0.0062 | 0.0074 | 0.0143 | 0.0034 | 0.0166 | 0.0136 | 0.0104 | 0.0193 | 0.0086 | 0.0062 |
| Nucleolus | 0.009 | 0.0081 | 0.0076 | 0.0082 | 0.019 | 0.0122 | 0.0072 | 0.0063 | 0.0055 | 0.0049 | 0.0079 | 0.0132 | 0.0127 | 0.0097 | 0.0092 | 0.009 | 0.0154 | 0.0152 |
| Nucleus | 0.7919 | 0.7515 | 0.8281 | 0.8105 | 0.7434 | 0.8842 | 0.8773 | 0.8607 | 0.9271 | 0.8998 | 0.8738 | 0.9067 | 0.74 | 0.6257 | 0.7248 | 0.7022 | 0.6113 | 0.8279 |
| Peroxisomes | 0.0013 | 0.0002 | 0 | 0 | 0 | 0 | 0.0001 | 0 | 0 | 0 | 0 | 0.0001 | 0.0028 | 0.0017 | 0.0058 | 0.0125 | 0.0038 | 0.0069 |
| Punctate Nuclear | 0.0491 | 0.0554 | 0.0413 | 0.1012 | 0.0731 | 0.0524 | 0.025 | 0.0316 | 0.0249 | 0.0265 | 0.0208 | 0.0399 | 0.0305 | 0.0422 | 0.0473 | 0.0616 | 0.086 | 0.0428 |
| Vacuole | 0.002 | 0.0016 | 0.0006 | 0.0003 | 0.0005 | 0.0002 | 0.0004 | 0.0008 | 0.0002 | 0.0004 | 0.0004 | 0.0003 | 0.0018 | 0.0022 | 0.0098 | 0.0032 | 0.0014 | 0.0006 |
| Vacuole Periphery | 0.001 | 0.0006 | 0.0002 | 0.0002 | 0.0003 | 0.0001 | 0.0002 | 0.0002 | 0.0001 | 0.0002 | 0.0003 | 0.0001 | 0.0008 | 0.0003 | 0.0007 | 0.001 | 0.0003 | 0.0002 |
Sequencing Data
| R1 | R2 | |||||||||
|---|---|---|---|---|---|---|---|---|---|---|
| G1 Post-START | S/G2 | Metaphase | Anaphase | Telophase | G1 Post-START | S/G2 | Metaphase | Anaphase | Telophase | |
| Gene Expression | 16.5304 | 35.0958 | 19.1893 | 16.7075 | 17.4138 | 6.1955 | 19.6103 | 17.6475 | 14.1468 | 18.895 |
| Translational Efficiency | 0.9439 | 0.5649 | 0.9112 | 0.9488 | 0.9628 | 2.6206 | 0.7907 | 1.2553 | 1.3563 | 0.8336 |
Hit Data
| Dataset | Hit |
|---|---|
| Protein Concentration | ✘ |
| Protein Localization | ✘ |
| Gene Expression | ✘ |
| Translational Efficiency | ✘ |
Endocytosis
| Temp | Actin Patch (Sac6-tdTomato) | Cortical Patch (Sla1-GFP) | Late Endosome (Snf7-GFP) | Vacuole (Vph1-GFP) |
|---|---|---|---|---|
| 37℃ | ||||
| RT |
Cell Cycle Omics
CYCLoPs (Met31-GFP)
| Gene / Allele | Actin Patch (Sac6-tdTomato) | Cortical Patch (Sla1-GFP) | Late Endosome (Snf7-GFP) | Vacuole (Sac6-tdTomato) |
|---|
| Gene | Images |
|---|
| Gene | Images |
|---|
Images are not yet available
Images are not yet available